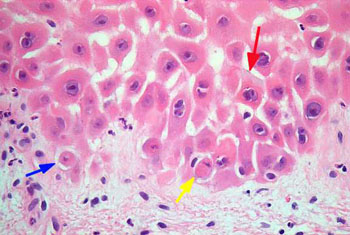

胰高血糖素瘤的病理
作者:匿名
来源:癌症救助网
时间:2010-09-26 00:53:47
胰高血糖素瘤的病理
1.胰高血糖素瘤的瘤体较其他功能性内分泌肿瘤都大,其直径为3~35cm,且大多数为单发肿瘤,多发性者仅为2~4%。恶性者占60~82%。50%以上的病人在诊断时已经远处转移,最常见转移部位是肝脏和淋巴结,但也有转移至骨和肾上腺者。胰高血糖素瘤几乎都发生在胰腺,其中50%位于胰尾、38%位于胰体、12%在胰头。
2.组织学检查,镜下胰高血糖素瘤为分化较好的内分泌肿瘤形态,没有显著的特征性改变。尽管大多数为癌瘤,而有丝分裂相或核异形性却少见。免疫组织化学染色显示含胰高血糖素颗粒阳性,提示肿瘤来源于胰岛A细胞,电子显微镜检查显示肿瘤细胞内含有数量不等的分泌性颗粒,通常良性者细胞内充满这种颗粒,而恶性者颗粒数量明显减少。
3.本病的皮肤病理主要表现为表皮棘细胞层坏死溶解,并导致大疱性破裂,在表皮层的血管周围有少量淋巴细胞浸润。在病程较久的病变组织中,表现为非特异性皮炎样改变,有不规则的棘皮症伴海绵层水肿,梭状角质细胞伴核固缩,免疫荧光检查阴性。

责任编辑: 王丹
癌症百问:
- 食管癌:食疗偏方
- 食道癌的食疗偏方
- 中医治疗食道癌5处方
- 食道癌:生芦根粥
- 食管癌:青礞石方(内服)
- 食管癌:民间偏方治疗法
- 食管癌:加味地黄汤(内服)
- 食管癌:健脾益气饮(内服)
- 食管癌:旋复代赭汤(内服)
- 食管癌:魔芋半夏汤(内服)
热点推荐:
Copyright © 2008-2021 www.ikcw.com 版权所有 癌症救助网 - 中国(慈善救助)癌症患者第一门户网站 未经授权请勿转载
互联网药品信息服务许可证 互联网医疗卫生信息服务许可证 京ICP备08101493号 京公网安备11010502022924
十年树木,百年树人。癌症救助网,坚持公益,坚持救助,做国际慈善癌症救助网络平台!

互联网药品信息服务许可证 互联网医疗卫生信息服务许可证 京ICP备08101493号 京公网安备11010502022924
十年树木,百年树人。癌症救助网,坚持公益,坚持救助,做国际慈善癌症救助网络平台!











